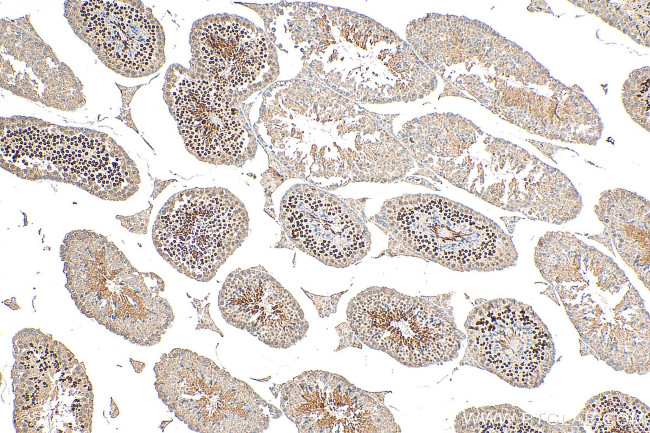
PCGF6 Antibody in Immunohistochemistry (Paraffin) (IHC (P))

Search
Proteintech
PCGF6 Polyclonal Antibody
{{$productOrderCtrl.translations['antibody.pdp.commerceCard.promotion.promotions']}}
{{$productOrderCtrl.translations['antibody.pdp.commerceCard.promotion.viewpromo']}}
{{$productOrderCtrl.translations['antibody.pdp.commerceCard.promotion.promocode']}}: {{promo.promoCode}} {{promo.promoTitle}} {{promo.promoDescription}}. {{$productOrderCtrl.translations['antibody.pdp.commerceCard.promotion.learnmore']}}
产品信息
24103-1-AP
种属反应
已发表种属
宿主/亚型
分类
类型
抗原
偶联物
形式
浓度
规格
纯化类型
保存液
内含物
保存条件
运输条件
产品详细信息
Immunogen sequence: MEGVAVVTA GSVGAAKTEG AAALPPPPPP PVSPPALTPA PAAGEEGPAP LSETGAPGCS GSRPPELEPE RSLGRFRGRF EDEDEELEEE EELEEEEEEE EEDMSHFSLR LEGGRQDSED EEERLINLSE LTPYILCSIC KGYLIDATTI TECLHTFCKS CIVRHFYYSN RCPKCNIVVH QTQPLYNIRL DRQLQDIVYK LVINLEEREK KQMHDFYKER GLEVPKPAVP QPVPSSKGRS KKVLESVFRI PPELDMSLLL EFIGANEGTG HFKPLEKKFV RVSGEATIGH VEKFLRRKMG LDPACQVDII CGDHLLEQYQ TLREIRRAIG DAAMQDGLLV LHYGLVVSPL KIT (1-352 aa encoded by BC010235)
靶标信息
Polycomb group (PcG) proteins form multiprotein complexes that regulate expression patterns of developmental and cell proliferation genes. Several members of the PcG contain ring finger domains and are identified as a subclass of RING finger proteins. The RING-type zinc finger motif is present in a number of viral and eukaryotic proteins and is made of a conserved cysteine-rich domain that is able to bind two zinc atoms. Proteins that contain the RING-type zinc finger conserved domain are generally involved in the ubiquitination pathway of protein degradation. PCGF6 (polycomb group ring finger 6), also known as MBLR or RNF134, is a 350 amino acid nuclear protein that is ubiquitously expressed and contains one RING-type zinc finger. PCGF6 acts as a transcriptional repressor and regulates the level of histone H3K4Me3 by activating SmcY histone demethylase. PCGF6 exists as two alternatively spliced isoforms.
仅用于科研。不用于诊断过程。未经明确授权不得转售。
生物信息学
蛋白别名: hMBLR; Mel18 and Bmi1-like RING finger; Mel18 and Bmi1-like RING finger protein; Mel18- and Bmi1-like RING finger protein; Polycomb group RING finger protein 6; RING finger protein 134; unnamed protein product
基因别名: 4933407A11Rik; AI604840; MBLR; PCGF6; RNF134
UniProt ID: (Human) Q9BYE7, (Mouse) Q99NA9
Entrez Gene ID: (Human) 84108, (Mouse) 71041